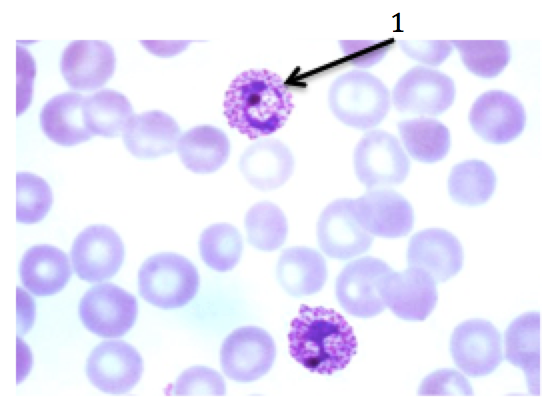

Name the 4 supergroups
- Excavata
- SAR Clade
- Archaeplastida
- Unikonta
What are the subgroups and groups of Excavata?
- Diplomonads
- Eugelnozoans
- Euglenids
- Kinetoplastids
What is a unique feature of diplomonads from the Excavata supergorup?
Modified (highly reduced) mitochondira
What is a unique feature of euglenids and kinetoplastids from the Excavata supergorup?
Spiral/crystalline rod flagella
a) What supergorup, subgroup, and group is this organism?
b) Identify the structure at the end of pointers 1 and 2

a) Excavata, diplomonads
b) 1 = nuclei
2 = flagella
a) What supergorup, subgroup, and group is this organism?
b) Identify the structure at the end of pointers 1, 2 and 3.

a) Excavata, euglenozoans, euglenids
b) 1 = long flagellum
2 = contractile vacuole
3 = pellicle
a) What supergorup, subgroup, and group is this organism?
b) Identify the structure at the end of pointers 1, 2 and 3.

a) Excavata, euglenozoans, kinetoplastids
What are the subgroups and groups of the SAR Clade?
- Stramenopiles
- Diatoms
- Brown Algae
- Gold Algae - Alveolates
- Dinoflagellates
- Apicomplexans
- Ciliates - Rhizarians
- Radiolarians
- Forams
What is a unique feature of stramenopiles?
Hairy and smooth flagella
What is a unique feature of dinoflagellates (from alveolates in the SAR Clade)?
Bioluminsecent
What is a unique feature of rhizarians?
Amoebas with thread-like pseudopodia
a) What supergorup, subgroup, and group is this organism?
b) Identify the structure at the end of pointers 1 and 2

a) SAR Clade, stramenopiles, diatoms
b) 1 = pennales
2 = centrales
a) What supergorup, subgroup, and group is this organism?
b) Identify the structure at the end of pointers 1, 2, 3 and 4.

a) SAR Clade, stramenopiles, brown algae
b) 1 = blade
2 = gad bladder
3 = stipe
4 = holdfast
a) What supergorup, subgroup, and group is this organism?
b) Identify the structure at the end of pointers 1 and 2.

a) SAR Clade, alveolates, dinoflagellates
b) 1 = multiple flagella
2 = nucleus
a) What supergorup, subgroup, and group is this organism?
b) Identify the structure at the end of the pointer.
a) SAR Clade, alveolates, apicomplexans
b) 1 = malarial cell
a) What supergorup, subgroup, and group is this organism?
b) Identify the structure at the end of pointers 1, 2 and 3.

a) SAR Clade, alveolates, ciliates
b) 1 = cilia
2 = micronucleus
3 = macronucleus
a) What supergorup, subgroup, and group is this organism?
b) Identify the structure at the end of the pointer.

a) SAR Clade, rhizarians, radiolarians
b) 1 = pseudopodia
a) What supergorup, subgroup, and group is this organism?
b) Identify the structure at the end of the pointer.

a) SAR Clade, rhizarians, forams
b) 1 = pseudopods
What are the subgroups and groups of Archaeplastida?
- Red Algae (Phylum Rhodophyta)
- Green Algae
- Chlorophyta
- Charophyta
- Land Plants
What is a unique feature of red algae (from archaeplastida)?
Pigment phycoerythrin absorbs blue light and reflects red
What is a unique feature of green algae (from archaeplastida)?
Plant-type chloroplasts
a) What supergorup and subgroup is this organism?

a) Archaeplastida, red algae
a) What supergorup, subgroup, and group is this organism?

a) Archaeplastida, green algae, chlorophyta
a) What supergorup, subgroup, and group is this organism?

a) Archaeplastida, green algae, charophyta




